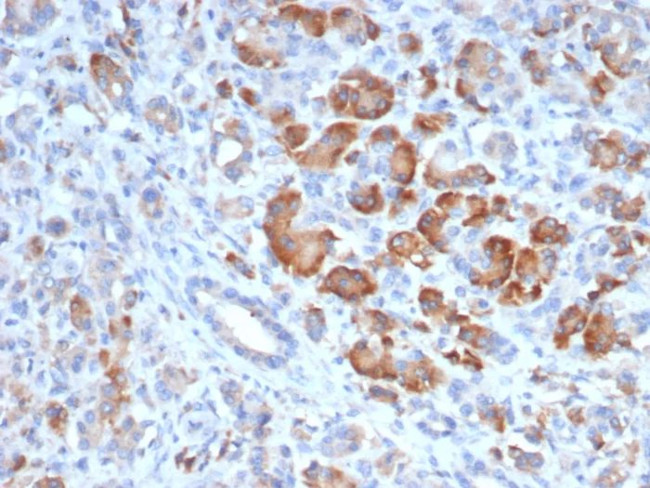
TRPC6/Transient Receptor Potential Cation Channel Subfamily C Member 6 Antibody in Immunohistochemistry (Paraffin) (IHC (P))

Search
NeoBiotechnologies
TRPC6/Transient Receptor Potential Cation Channel Subfamily C Member 6 Monoclonal Antibody (TRPC6/7672)
{{$productOrderCtrl.translations['antibody.pdp.commerceCard.promotion.promotions']}}
{{$productOrderCtrl.translations['antibody.pdp.commerceCard.promotion.viewpromo']}}
{{$productOrderCtrl.translations['antibody.pdp.commerceCard.promotion.promocode']}}: {{promo.promoCode}} {{promo.promoTitle}} {{promo.promoDescription}}. {{$productOrderCtrl.translations['antibody.pdp.commerceCard.promotion.learnmore']}}
产品信息
7225-MSM2-P1ABX
种属反应
宿主/亚型
分类
类型
克隆号
抗原
偶联物
形式
浓度
规格
纯化类型
保存液
内含物
保存条件
运输条件
产品详细信息
Positive Control: Human adrenal cortex pancreas or brain.
Cellular Location: Cell surface.
靶标信息
Trpc6 forms a receptor-activated calcium channel in the cell membrane. The Trpc6 channel is activated by diacylglycerol and is thought to be under the control of a phosphatidylinositol second messenger system. Activation of the Trpc6 channel occurs independently of protein kinase C and is not triggered by low levels of intracellular calcium. Defects in the Trpc6 gene are a cause of focal segmental glomerulosclerosis 2 (FSGS2). Further, Trpc6 is a member of the mammalian transient receptor potential (TRP) superfamily can be divided into three major families including the 'canonical TRP' (TRPC) family. The seven members of this family share the activation through PLC-coupled receptors and have been suggested to be components of receptor-regulated cation channels in different cell types. Furthermore, the members of the TRPC6/6/7 subfamily can be activated by diacylglycerol (DAG) analogs, suggesting a possible mechanism of activation of these channels by PLC-coupled receptors. When expressed in transfected cells, Trpc6 acts as a non-selective store-independent receptor-activated cation channel. Trpc6 is activated by DAG in a PKC-independent manner and is insensitive to IP3 activation. There is increasing evidence that Trpc6 encodes endogenous DAG-activated receptor-operated cation channels in vivo. Diseases associated with TRPC6 include Glomerulosclerosis, Focal Segmental, 2 and Focal Segmental Glomerulosclerosis.
仅用于科研。不用于诊断过程。未经明确授权不得转售。
篇参考文献 (0)
生物信息学
蛋白别名: FLJ11098; FLJ14863; focal segmental glomerulosclerosis 2; HGNC:12338; Short transient receptor potential channel 6; Transient receptor protein 6; TRP-6; TRP6; similar to Drosophila melanogaster transient receptor potential protein; trp6A; TrpC6; unnamed protein product
基因别名: FSGS2; TRP6; TRPC6
UniProt ID: (Human) Q9Y210
Entrez Gene ID: (Human) 7225